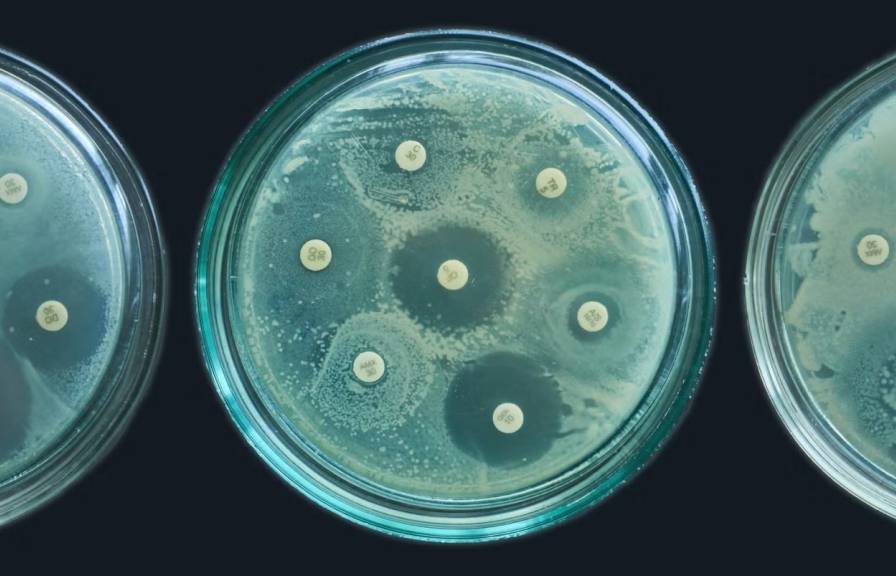
an antimicrobial resistance test in petri dishes

You might not know it, but there’s a good chance that you or someone you care about has benefited from health care innovations that got their start at the University of California.
From saving stroke patients to combating cancer, UC medical breakthroughs reach far beyond our state, enabling lifesaving treatments for people across the country and around the world.
Redefining what’s possible
Whether it’s curing the rarest diseases or developing new treatments for conditions that affect large swaths of Americans, UC medical innovations have a life-changing impact for millions of people.

Cracking the code on Alzheimer’s disease
Over 7 million Americans are living with Alzheimer’s, a disease that devastates families and costs the nation hundreds of billions each year. Researchers at multiple UC campuses are working to develop treatments that could radically change that picture.
From UC Irvine, ‘brain cleaning’ removes Alzheimer’s proteins
Helping premature babies survive
Babies born before 28 weeks typically can’t breathe on their own because they can’t yet make surfactant, a slippery substance that lubricates the lung tissue. Throughout history, most babies born before the third trimester died within a few hours — until a scientist at UC San Francisco figured out how to help them breathe. Thanks to UC medicine, the survival rate for these preemies has gone from 5 percent in the 1960s to 90 percent today.


Giving new hope to millions of cancer patients
20 million new cancer cases are diagnosed around the world each year, with some 2 million of those in the United States alone. Across the UC system, researchers are battling the disease, using the tools of science to create the treatments of the future, today.

Restoring the ability to speak
For those silenced by paralysis from spinal cord injury, stroke or ALS, a new brain-computer interface developed at UC Davis restores the vital ability to communicate. The most accurate system of its kind, it turns brain signals into speech, a life-changing development for patients and their families.
Leading the way in American health care innovation

For stroke, it’s the difference between life and death
Every 40 seconds, somebody in the U.S. has a stroke, which occurs after blood flow to the brain is interrupted by a blood clot. Developed at UC San Diego, the intravenous drug tPA dissolves the blood clots that cause strokes, significantly reducing the chance of death or long-term neurological damage.
Clinical trials and the next generation of cures
Hypertension, heart disease, diabetes. Alzheimer’s, Parkinson’s, cancer. Across its system, the University of California conducts nearly 5,000 clinical trials a year in its quest to find new treatments and cures for complex medical conditions.



Working toward the world’s first bioartificial kidney
One in seven adults in the U.S. suffers from chronic kidney disease. For those who progress to end-stage disease, some 550,000 are on dialysis, and more than 90,000 are on the waiting list for a kidney transplant. Working against those numbers, scientists at UC San Francisco are developing an artificial kidney that could free patients from dialysis and the excruciating wait for a transplant.
Expanding the frontiers of medicine
Read about just a few of the thousands of health care innovations researchers are working on across the University of California system.

Breast cancer treatment advances with light-activated ‘smart bomb’
Scientists at UC Riverside have developed new light-sensitive chemicals that can radically improve the treatment of aggressive cancers with minimal side effects. In mouse tests, the new therapy completely eradicated metastatic breast cancer tumors.
Overcoming drug-resistant bacteria
Researchers at UC Santa Barbara have discovered the basis for a new class of antibiotics, one that shows promise against a broad array of bacterial infections and can also evade the drug resistance that has been rendering the current generation of first-line antibiotics ineffective.

Gene therapy for sickle cell disease
UC San Francisco has launched a clinical trial that seeks to cure sickle cell disease, a genetic blood disorder resulting in anemia, pain, organ failure and a shortened life span. It’s the first trial in the country to use CRISPR gene-editing to directly correct the mutation that causes the disease.

Scanning the whole body, all at once
Developed at UC Davis, the world’s first total-body PET scanner can image the entire human body in seconds, delivering extraordinarily detailed images with far less radiation. It’s transformational for the early detection of cancer, infection, neurological disorders, heart disease and more.

A surgical procedure without the surgery
UC Irvine professor of ophthalmology and biomedical engineering Tibor Juhasz spent 25 years perfecting a laser treatment for glaucoma. Now it’s ready to change how the world sees.

Detecting disease with only a single molecule
UC Riverside scientists have developed a tool that could help diagnose illnesses much faster and with greater precision than current tests allow. The new technology captures signals from individual molecules instead of millions.
